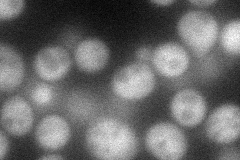
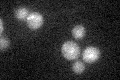

View description
Conserved protein that interacts with Atg12p-Atg5p conjugates to form Atg12p-Atg5p-Atg16p multimers, which localize to the pre-autophagosomal structure and are required for autophagy
Localization:
Intensity:
Fold change:
Significance:
-
C’ GFP library in SD

cytosol23.09 -
N' NOP1pr-GFP in SD
cytosol55.944 -
N' TEF2pr-mCherry in SD

cytosol94.753 -
N' NATIVEpr-GFP in SD

below threshold19.477 -
N' TEF2pr-VC and Cyto-VN in SD

cytosol42.8896 -
C’ GFP library in SD+DTT

cytosol23.731.02No -
C’ GFP library in SD+H2O2

cytosol20.780.89No -
C’ GFP library in Starvation Media
cytosol22.350.96No -
C’ GFP library on the background of Pup2-DaMP

cytosol -
C’ GFP library on the background of CCT mutant

cytosol20.14620.872359No
